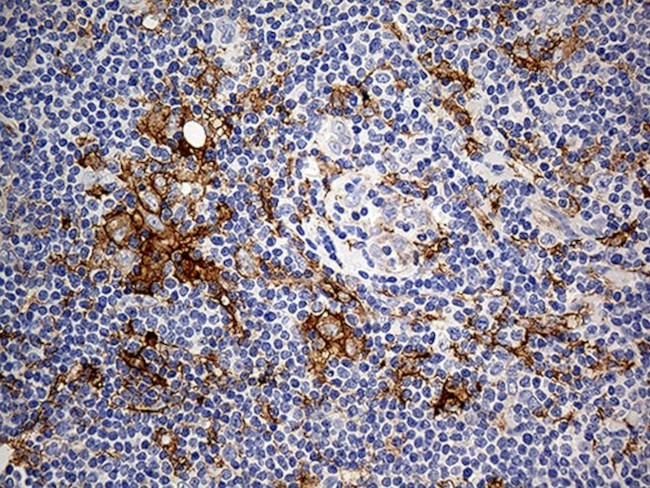
CD14 Antibody in Immunohistochemistry (Paraffin) (IHC (P))
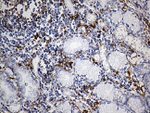
CD14 Antibody in Immunohistochemistry (Paraffin) (IHC (P))

Search
OriGene
CD14 Monoclonal Antibody (OTI3F5), TrueMAB™
{{$productOrderCtrl.translations['antibody.pdp.commerceCard.promotion.promotions']}}
{{$productOrderCtrl.translations['antibody.pdp.commerceCard.promotion.viewpromo']}}
{{$productOrderCtrl.translations['antibody.pdp.commerceCard.promotion.promocode']}}: {{promo.promoCode}} {{promo.promoTitle}} {{promo.promoDescription}}. {{$productOrderCtrl.translations['antibody.pdp.commerceCard.promotion.learnmore']}}
产品信息
TA811518
种属反应
宿主/亚型
分类
类型
克隆号
抗原
偶联物
形式
浓度
纯化类型
保存液
内含物
保存条件
运输条件
靶标信息
CD14 is a 55 kDa GPI-anchored glycoprotein that is constitutively expressed on the surface of mature monocytes, macrophages, and neutrophils. CD14 also serves as a multifunctional lipopolysaccharide receptor, and is released to the serum both as a secreted and enzymatically cleaved GPI-anchored form. CD14 binds lipopolysaccharide molecule in a reaction catalyzed by lipopolysaccharide-binding protein (LBP), an acute phase serum protein. The soluble sCD14 can discriminate slight structural differences between lipopolysaccharides and is important for neutralization of serum allochthonous lipopolysaccharides by reconstituted lipoprotein particles. Further, CD14 has been shown to bind apoptotic cells, and can affect allergic, inflammatory and infectious processes. Alternative splicing results in multiple transcript variants encoding the same CD14 isoform. Diseases associated with CD14 dysfunction include mycobacterium chelonae infection and Croup.
仅用于科研。不用于诊断过程。未经明确授权不得转售。
篇参考文献 (0)
生物信息学
蛋白别名: CD 14; CD14; cd14 monocyte; LPSR antibody; Monocyte differentiation antigen CD14; My23 antigen; Myeloid cell-specific leucine-rich glycoprotein; sCD14; soluble CD14
基因别名: CD14
UniProt ID: (Human) P08571
Entrez Gene ID: (Human) 929